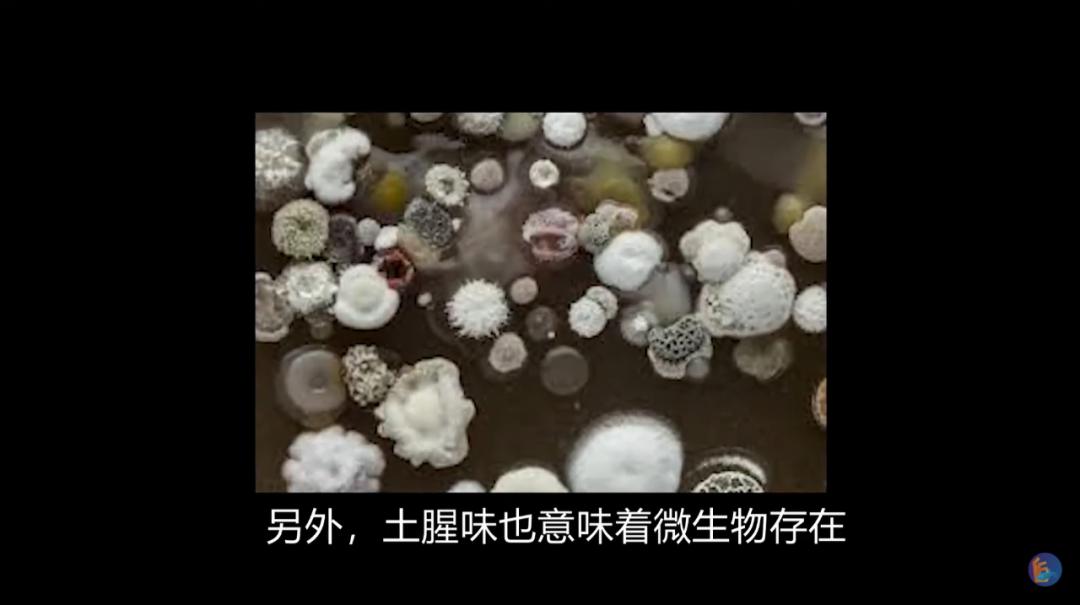
吃鱼有腥味如何去除,吃鱼有腥味怎么去

深 知养殖从业不易,共谋水产行业繁荣。不误导不夸大不炒作不标题*党**。用养殖人的语境,让你在短时间内享用一份精品!

在土腥味这件事上,淡水鱼是妥妥的背锅侠。 土腥味的罪魁祸首其实是水中的蓝藻、绿藻、硅藻和住在淤泥里的放线菌!它们会向水体释放以土臭素(geosmin)与2-甲基异莰醇(2-methylisoboneol)为主的土腥味物质,这些物质在鱼体中富集,成功让淡水鱼“腌制入味”。

不过,当土腥味物质稀释到一定浓度,你并不会觉得臭。比如下过雨后清新的潮土味,比如你女朋友的解放橘郡-赫曼如影,臭与香其实不过是一念之间。就像是粑粑臭味成分之一的吲哚, 高浓度时是粑粑味,低浓度时就是茉莉花的香味。如果你想自制茉莉花香水,可以通过煮翔提炼吲哚,然后用酒精稀释千倍,bingo!配上一个精致的玻璃瓶,送给挚爱的朋友,友情一定能天长地久!

好啦,说回土腥味。土腥味物质亲脂性强,喜欢做脂肪的舔狗,几分钟就能从水体透过腮和消化道进入鱼的脂肪,让鱼有“内味儿”。鱼需要花几天的时间才能把它们排出体外,而它们偏偏又难溶于水,待在水里阴魂不散,逮住机会又会往鱼身上蹭,长此以往便顺利地和鱼长相厮守,鱼越大越肥,脂肪越多,味道就越重。

在追求脂肪的道路上,土腥味物质们可谓来者不拒,什么阿鸡、阿牛,长期喝有土腥味的水,产的蛋和奶也都会带上土腥味。这土腥味的奶,绝对是吃土患者的福音,每日一杯,从内到外,芳香永存,舒坦!

虽然土腥味们狗狗祟祟,但人类对它们的反侦察能力也不是盖的。只要一点点的含量,你就会发现它们的存在。举个例子,有人坐火车时,放了一个臭鸡蛋味、全是硫化氢的屁,可以把整个车厢人都臭晕,如果把硫化氢换成土腥味物质,那这个屁可以恶心400节车厢的人。
即使它们掩藏在鱼肉中,鼻子的反侦察能力依旧很强, 以鲤鱼为例,每斤鱼肉中土腥味物质的量超过0.00000025克,你就不会馋鱼的身子,甚至感觉鱼对你另有所图了;超过0.00001克,你就想请专业团队了。

为什么我们对土腥味物质的侦查能力这么强?这是一个关于生物演化和生存哲学的问题!
喜欢生活在潮湿环境中的放线菌在生孢子的同时,释放土腥味物质,部分生物如骆驼,可以通过追踪土腥味,在荒漠中寻找到水源,喝了水的骆驼就成了孢子的免费巴士,帮助放线菌进行种群扩散。

另外,土腥味也意味着微生物存在,以酵母为食的果蝇就可以依靠对土腥味的厌恶,在一堆腐烂的水果中精准地找到没有被微生物覆盖的酵母,来避免吃到有毒的微生物(链球菌、青霉菌)。下次大家再闻到这个味道时,不能只想到难闻,要感受到生物演化、生存哲学的力量!
养殖淡水鱼的土腥味往往更重,因为它们一般在静态的水体中进行养殖。这些水体的水质容易富营养化,成为微生物绝佳的培养基,水温升高,口粮充足,微生物们享受自由恋爱,不考虑计划生育,土腥味物质产量形势一片大好。

要养出没有土腥味的淡水鱼,办法也不是没有:积极控制水体的微生物生长,或者告别土塘,用水泥池或地膜池养殖, 也可以在卖鱼前把鱼转移到干净水体度个假,都有助于洗刷土腥味的屈辱。只是以上这些做法成本较高,鱼的价格也会贵一点点,轻奢,轻奢。
当然,如果像我一样穷得吃土,土都吃了,还怕啥土腥味?疫情期间苦练多日的厨艺不是白学的,用料酒、香醋来个互溶萃取,用煎炸来个加速挥发,再加上花椒大料,绝对真香!
(来源:智渔)

水产实践人士,共谋渔业繁荣!敬请关注我的头条号@渔人刘文俊,更多精彩内容请登录西南渔业网和养鱼第一线公众号,本文原创如需转载请注明出处,如有不同见解或者内容补充请私信或留言或评论分享!#水产养殖##科学燃计划##我要上微头条##淡水鱼##鱼#